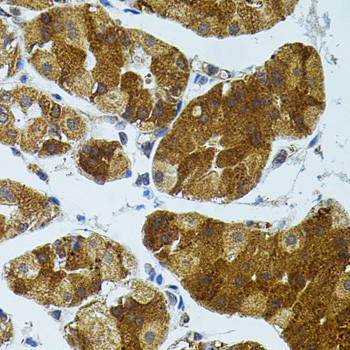
CETP Antibody in Immunohistochemistry (Paraffin) (IHC (P))

Search
Invitrogen
CETP Polyclonal Antibody
{{$productOrderCtrl.translations['antibody.pdp.commerceCard.promotion.promotions']}}
{{$productOrderCtrl.translations['antibody.pdp.commerceCard.promotion.viewpromo']}}
{{$productOrderCtrl.translations['antibody.pdp.commerceCard.promotion.promocode']}}: {{promo.promoCode}} {{promo.promoTitle}} {{promo.promoDescription}}. {{$productOrderCtrl.translations['antibody.pdp.commerceCard.promotion.learnmore']}}
图: 1 / 2
CETP Antibody (PA5-89297) in IHC (P)


Please note: We are reviewing Western blot images included in the antibody testing data in our catalog, including those provided by third parties. Unless expressly labeled or annotated as “raw-unedited”, Western blot images included in the antibody testing data in our catalog may have been edited, optimized or otherwise adjusted for presentation.
产品信息
PA5-89297
种属反应
宿主/亚型
分类
类型
抗原
偶联物
形式
浓度
规格
纯化类型
保存液
内含物
保存条件
运输条件
RRID
产品详细信息
Immunogen sequence: LMLSLMGDEF KAVLETWGFN TNQEIFQEVV GGFPSQAQVT VHCLKMPKIS CQNKGVVVNS SVMVKFLFPR PDQQHSVAYT FEEDIVTTVQ ASYSKKKLFL SLLDFQITPK TVSNLTESSS ESVQSFLQSM ITAVGIPEVM SRLEVVFTAL MNSKGVSLFD IINPEIITRD GFLLLQMDFG FPEHLLVDFL QSLS; Positive Samples: A-549, HepG2, A375, Mouse liver, Rat liver; Cellular Location: extracellular space
靶标信息
It has been proposed that high density lipoproteins (HDLs) function jointly with lecithin:cholesterol acyltransferase and CETP to facilitate cholesterol transport from tissues to the liver. This mechanism, referred to as reverse cholesterol transport, is physiologically important because it maintains systemic cholesterol levels. CETP is responsible for neutral lipid transfer activity in plasma in numerous species. Since CETP is able to accelerate specifically the exchange of lipid components between pro- and anti-atherogenic lipoprotein fractions, it may be a key determinant of the global atherogenicity of the plasma lipoprotein profile and arises as a possible target in atherosclerosis prevention. CETP has an important role in reverse cholesterol transport and shaping and affecting the composition of plasma lipoproteins. In general elevated levels of CETP have been associated with increased risk of coronary heart disease.
仅用于科研。不用于诊断过程。未经明确授权不得转售。
篇参考文献 (0)
生物信息学
蛋白别名: BPI fold containing family F; Cholesteryl ester transfer protein; cholesteryl ester transfer protein plasma; cholesteryl ester transfer protein precursor; Lipid transfer protein I; unnamed protein product
基因别名: BPIFF; CETP; HDLCQ10
Entrez Gene ID: (Human) 1071